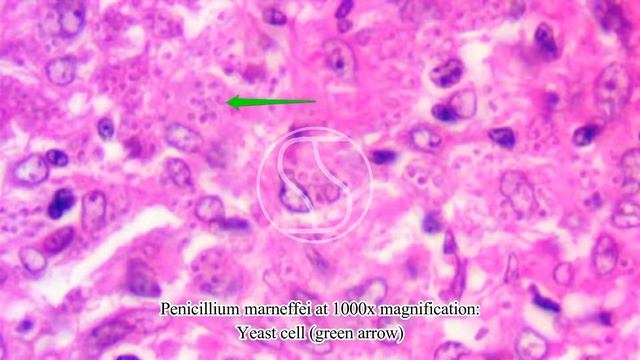
Penicillium marneffei under the microscope with Haematoxylin and Eosin (H&E) stain смотреть онлайн

Автор / Канал: Лесная мечта Страница 3

Mucor/Pin Mould

О, кто таков? Жмых

epidermophyton floccoum
Penicillium marneffei under the microscope with Haematoxylin and Eosin (H&E) stain

Tradd Cotter - Mushroom Mountain

Сморчковая шапочка

приёмник СССР VEF 202 cFM + блютуз колонка

Местное время 24.10.22

НОВОГОДНИЙ СТРИМ | ИГРАЕМ НА СКАЙВАРС И БЕДВАРС

Грибы - Любовь

крутой симулятор бурения 1 серия roblox Simulator

масленица

Polysaccharides

Champi y los Monguis ; Quisiera

Kadhi pakora recipe |पंजाबी पकौड़ा कढ़ी | Swad Maa ki Rasoi se

Reflor Kapsül Nedir? Yan Etkileri Nelerdir Ve Ne İçin Kullanılır...

Đông Trùng Hạ Thảo Cordyceps 950

🍫TRUFFLE🍫II ASMR II SATISFYING II SHORTS II YOUTUBE SHORTS II SHORTS VIDEO II ETHEL ALLERA

Играем во что либо и опять 2 стрим за 1 день! (опять то-же

Отличный трофей #мурманскаяобласть #shortstiktok #природа #видео #mashroom #грибы

ЛАВАШ С КУРИЦЕЙ И ШАМПИНЬОНАМИ

Приговор по «делу грибников»

играю в лисичку

27 октября утка ещё не улетела на юг. Новосибирск. В жарких странах (Секрет)Максим Чигинцев
За каждым успешным каналом стоит личность, идея и сотни часов кропотливого труда. Если вы здесь, значит, автор «Лесная мечта» уже сумел зацепить ваше внимание своим уникальным стилем или подачей. А мы на RUVIDEO позаботились о том, чтобы вы могли изучить весь архив его работ в максимально комфортных условиях — без лишней суеты и преград.
Почему за работами канала «Лесная мечта» так интересно наблюдать? Всё просто: это честный контент, который находит отклик в сердцах зрителей. На нашем ресурсе вы можете смотреть онлайн все видео любимого автора бесплатно и в хорошем качестве. Нам важно, чтобы вы видели каждую деталь и слышали каждый нюанс, поэтому мы используем только стабильные плееры из открытых источников Rutube.
Следите за новинками канала, пересматривайте старые шедевры и открывайте для себя новые грани творчества «Лесная мечта». Мы постоянно обновляем ленту, чтобы у вас под рукой всегда были самые свежие выпуски. Никаких сложных регистраций — только вы и творчество, которое вдохновляет. Приятного вам путешествия по миру авторского контента на RUVIDEO!
Видео взято из открытых источников Rutube. Если вы правообладатель, обратитесь к первоисточнику.